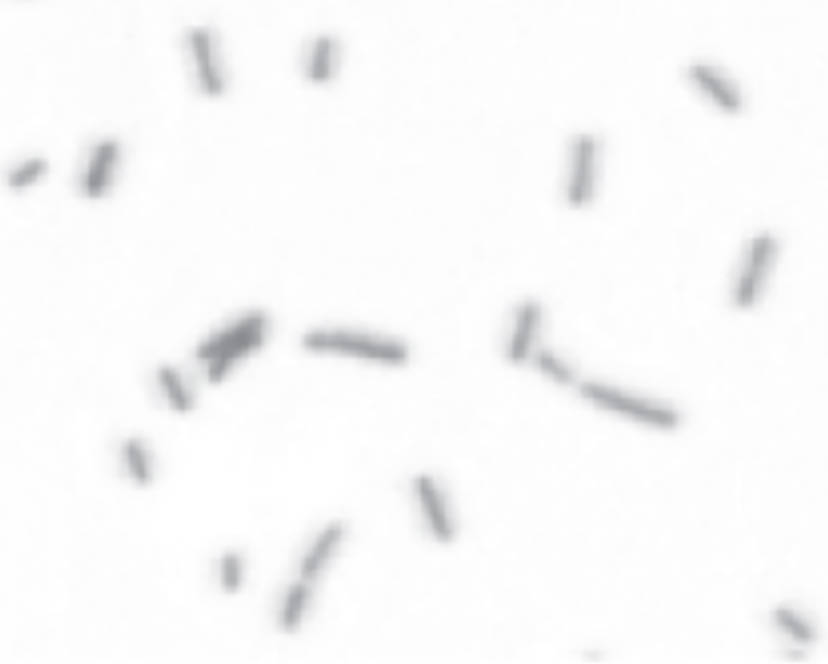

Coccobacilli represent a unique morphological middle ground between spherical cocci and rod-shaped bacilli. These microorganisms, often presenting as short, oval-shaped cells, include several significant human pathogens. Understanding their distinct anatomical features and the diseases they cause is essential for accurate laboratory identification and effective clinical treatment.
In the field of microbiology, cell shape is one of the most fundamental characteristics used for the classification of bacteria. A coccobacillus is a type of bacterium with a shape intermediate between cocci (spherical) and bacilli (rods). While they may appear as small dots under low magnification, higher resolution microscopy reveals their elongated, oval structure. This specific morphology is a defining trait for several genera that play critical roles in human health and disease.
The visualization of coccobacilli in clinical samples, such as blood, sputum, or cerebrospinal fluid, provides immediate diagnostic clues. However, because their shape is so short, they can frequently be misidentified as cocci, particularly if the staining process is not optimal. Accurate identification often requires a combination of high-magnification microscopy, specialized staining techniques like the Gram stain, and biochemical or molecular testing to confirm the species.
Several medically important bacteria exhibit this coccobacillary morphology, including:
- Haemophilus influenzae: A common cause of respiratory infections and bacterial meningitis in children.
- Bordetella pertussis: The causative agent of “whooping cough,” characterized by severe coughing fits.
- Brucella species: The cause of brucellosis, a zoonotic infection often transmitted through unpasteurized dairy.
- Yersinia pestis: The bacterium responsible for the plague.
- Chlamydia trachomatis: A prevalent sexually transmitted pathogen that exists as a tiny coccobacillus during its infectious stage.
Anatomical Characteristics and Physiological Adaptation
The anatomical structure of a coccobacillus is primarily dictated by its cell wall composition and its internal protein scaffold. Most medically relevant coccobacilli are Gram-negative, meaning they possess a thin layer of peptidoglycan situated between an inner cytoplasmic membrane and an outer lipopolysaccharide membrane. This complex envelope protects the organism from environmental stressors and contributes to its pathogenesis by releasing endotoxins that trigger inflammatory responses in the host.
Physiologically, the small, rounded-rod shape of these bacteria offers a balance between surface-area efficiency and structural resilience. Their size—often less than one micrometer in length—allows them to navigate through mucosal barriers or even live inside host cells (intracellularly), as seen with Brucella and Chlamydia. This ability to hide within host cells or occupy niche environments makes them particularly adept at causing chronic or persistent infections.
Focus on Disease: Bordetella pertussis and Whooping Cough
One of the most clinically significant coccobacilli is Bordetella pertussis, the pathogen responsible for pertussis, or whooping cough. This highly contagious respiratory disease is characterized by paroxysmal coughing episodes followed by a high-pitched “whoop” sound during inhalation. The bacterium utilizes specialized surface proteins called adhesins to attach themselves to the cilia of the human respiratory epithelium. Once attached, they release toxins that paralyze the cilia and cause intense inflammation.
The primary virulence factors of B. pertussis include pertussis toxin and tracheal cytotoxin. These toxins interfere with cellular signaling and damage the respiratory lining, leading to the accumulation of mucus and the characteristic violent cough. While widespread vaccination has significantly reduced the incidence of the disease, it remains a serious threat to infants who have not yet completed their primary vaccine series. Diagnosis is typically confirmed via PCR or culture from a nasopharyngeal swab, where the organism’s coccobacillary shape can be observed.
Diagnostic Challenges and Pleomorphism
In some instances, these bacteria may exhibit pleomorphism, a phenomenon where cells within the same population vary significantly in size and shape. Environmental factors, such as the age of the culture or the availability of nutrients, can cause a coccobacillus to look more like a distinct rod or a perfect sphere. This variability underscores the importance of standardized laboratory procedures and the expertise of clinical microbiologists in interpreting microscopic findings.
The microscopic identification of coccobacilli remains a cornerstone of infectious disease diagnosis. By recognizing the subtle nuances of bacterial morphology, healthcare providers can initiate appropriate empirical therapy more quickly, potentially improving patient outcomes. As we continue to refine our diagnostic tools, the foundational knowledge of these intermediate bacterial shapes remains indispensable to the practice of modern medicine and public health.

